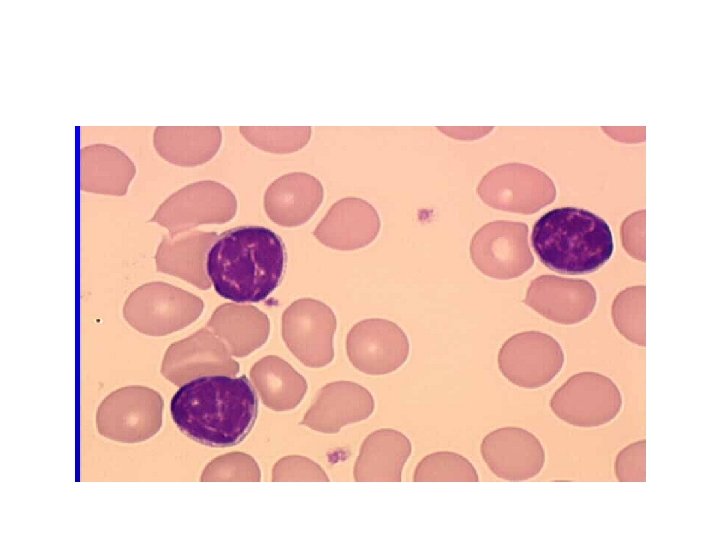

La Leucmie Lymphode Chronique INTRODUCTION La Leucmie Lymphode

- Slides: 20
La Leucémie Lymphoïde Chronique INTRODUCTION • La Leucémie Lymphoïde Chronique (LLC) est une prolifération lymphoïde monoclonale, Responsable d'une infiltration médullaire, sanguine, parfois ganglionnaire, constituée de. Lymphocytes matures de morphologie normale et de phénotype B. • C'est la plus fréquente des leucémies de l'adulte. Elle ne se rencontre pas chez l'enfant. • D’évolution chronique, la LLC reste une maladie incurable, mais de progression lente pour une large majorité des patients.
Classification Syndromes Lymphoprolif Chroniques • • • � Leucémie lymphoïde chronique � Leucémie à prolymphocytes � Leucémie à tricholeucocytes � Lymphome splénique à lymphocytes villeux � Phases leucémiques de lymphome
DIAGNOSTIC POSITIF • Survenant généralement après 50 ans, le début est souvent insidieux. • 1. 1 LES CIRCONSTANCES DE DÉCOUVERTE • ● La numération formule sanguine systématique est la circonstance de découverte la plus fréquente : elle objective une hyperlymphocytose. • ● Le syndrome tumoral : poly adénopathies, splénomégalie (rarement isolée) • ● Une complication infectieuse révélatrice : zona, pneumopathie récidivante … • ● Plus rarement les conséquences d'une cytopénie : anémie, thrombopénie.
I. 2 LES ÉLÉMENTS DU DIAGNOSTIC § I. 2. 1 La numération formule sanguine hyperlymphocytose • Elle est suffisante pour évoquer fortement le diagnostic dans la majorité des cas. Elle montre • une hyperlymphocytose le plus souvent isolée, d'importance variable (parfois très élevée), • Toujours supérieure à 5 G/L, persistant sur plusieurs examens au-delà de 6 -8 semaines. • Les lymphocytes sont le plus souvent de morphologie normale et monomorphes sur le Frottis de sang
III. Signes cliniques = syndrome tumoral - ADP : 70% des cas et précoces. Classiquement bilatérales, symétriques, indolores, mobiles. De taille modérée. L’importance de l’atteinte des différents territoires a une valeur pronostique importante dans la classification de Binet. Attention : l’augmentation rapide de la taille d’une ADP ou l’apparition de signes de compression doivent faire suspecter un syndrome de Richter. - SMG : 20% des cas Prise en compte dans les classifications pronostiques. De taille modérée - HMG : 5 à 10% des cas Comptabilisée comme un territoire ganglionnaire dans la classification de Binet
IV. Diagnostic biologique -1. Hémogramme - Lignée blanche Ølymphocytose> 5 g/l -Lignée rouge ØAnémie dans 8 à 10% des cas, Hb < 100 g/L. Normochrome normocytaire reticulocytes § réticulocytes renseigne sur le mécanisme. Arégénérative par insuffisance médullaire ou erytroblastopénie Régénérative par AHAI - Les plaquettes Thrombopénie dans 10% des cas, centrale ou auto-immune
Aspect cytologique des lymphocytes • Petits lymphocytes très proches des lymphocytes normaux • Dans 90 à 99% des cas, le rapport NC est élevé, le noyau et le cytoplasme sont de profil Régulier, la chromatine est dense et le nucléole est non visible. • Sur le frottis : cellules altérées et des noyaux nus appelés « ombres de Gümprecht » . • Il est fréquent d’observer des prolymphocytes (grande taille et nucléolées, chromatine plus claire). . • Il existe également la LLC mixte qui compte 20 à 30% de prolymphocytes
Aspect cytologique
Examens immunophénotypique Sur sang frais. • affirmer la LLC • Indispensable pour porter le diagnostic de LLC. • Existence de cellules B (CD 19, CD 20), exprimant les antigènes HLA de classe I et II. • monoclonales, exprimant de faibles taux d’Ig de membrane avec restriction dans les chaînes légères. • CD 79 b faiblement exprimé, ainsi que CD 22. • coexprimant CD 5 (marqueur T) et CD 23.
Score de Matutes :
Myélogramme §Infiltration de plus de 30% de la moelle par des cellules lymphocytaires d’aspect mature. Persistance des lignées érythroblastique, mégacaryocytaire et granuleuse. Biopsie Médullaire n’a pas d’indication
7. Bilan sérique • Electrophorèse des protéines • Test de coombs direct • Ionogramme avec dosage de créatinine, calcium, acide urique et glycémie • Bilan hépatique avec bilirubine • Dosage de LDH • Il peut exister une Ig. M monoclonale. • Test de Coombs positif : attention à l’utilisation des analogues des purines.
§ Facteurs pronostique § La classification pronostique la plus ancienne est clinique Classification de Rai (1975 ) États-Unis Classification de Binet (1981) Europe § Critères d’évolutivité du NCI (1996) § L’age § le sexe § LDT § Les facteurs biologiques: Marqueurs sériques(LDH, B 2 microglobuline) § Facteurs pronostiques immunophénotypiques Expression de CD 38 Expression de zap 70 Facteurs cytogénétiques- - délétion 13 q 14 - Trisomie 12 : 20% des cas - Délétion 11 q 22 -23 : 13 à 19% des anomalies ; mauvais pronostic - Délétion 6 q : 5% des cas - Mutation ou délétion de p 53 sur le chromosome 17
Pronostic.
Facteurs pronostiques Critères d’évolutivité du NCI Ø En 1996, le National Cancer Institute (NCI) a proposé une définition des formes agressives de la maladie, Sont considérées agressives les formes comportant au moins un signe suivant : Perte de poids > à 10 % dans les six Insuffisance médullaire (anémie ou derniers mois thrombopénie) Fatigue extrême (incapacité d'assurer les activités quotidiennes) Anémie auto-immune ou thrombopénie répondant mal aux corticoïdes Fièvre à 38 °C pendant 15 jours sans infection évidente Splénomégalie massive (d'au moins 6 cm au-dessous du rebord costal) Sueurs nocturnes sans preuve d'infection Augmentation rapide de la lymphocytose sanguine d'au moins 50 % en 2 mois ou temps de doublement inférieur à 6 mois
VIII. Traitement La LLC reste une maladie incurable -moyens thérapeutiques conventionnels -monochimiothérapies • Chlorambucil • Corticoïdes : effet de courte durée • Cyclophosphamide et busulfan • Chloraminophène : augmentation des infections • Polychimiothérapie. COP, MOPP, CHOP • analogues des purines : Fludarabine • essais d’intensification thérapeutique suivis d’autogreffe ou d’allogreffe de CSH = seul traitement curatif à ce jour.
Indications. Sont en fonction du stade Ø Stade A : ne pas traiter Ø Stades B et C: chymiotherapie type RFC; CHOP Traitement symptomatique : - antibiothérapie en cas de syndrome infectieux, - administrations régulières de gammaglobulines intraveineuses en cas d'hypogamma-globulinémie compliquée d'infections antérieures - transfusions sanguines en cas d'anémie mal tolérée.
Autre syndromeslymphoproliferatifs • Leucémie à prolymphocyte • Leucémie à tricholeucocytes • Phase leucémique des lymphomes folliculaires, lymphomes du manteau, lymphomes lymphoplasmocytaires • lymphomes spléniques à lymphocytes villeux, • lymphomes de la zone marginale).